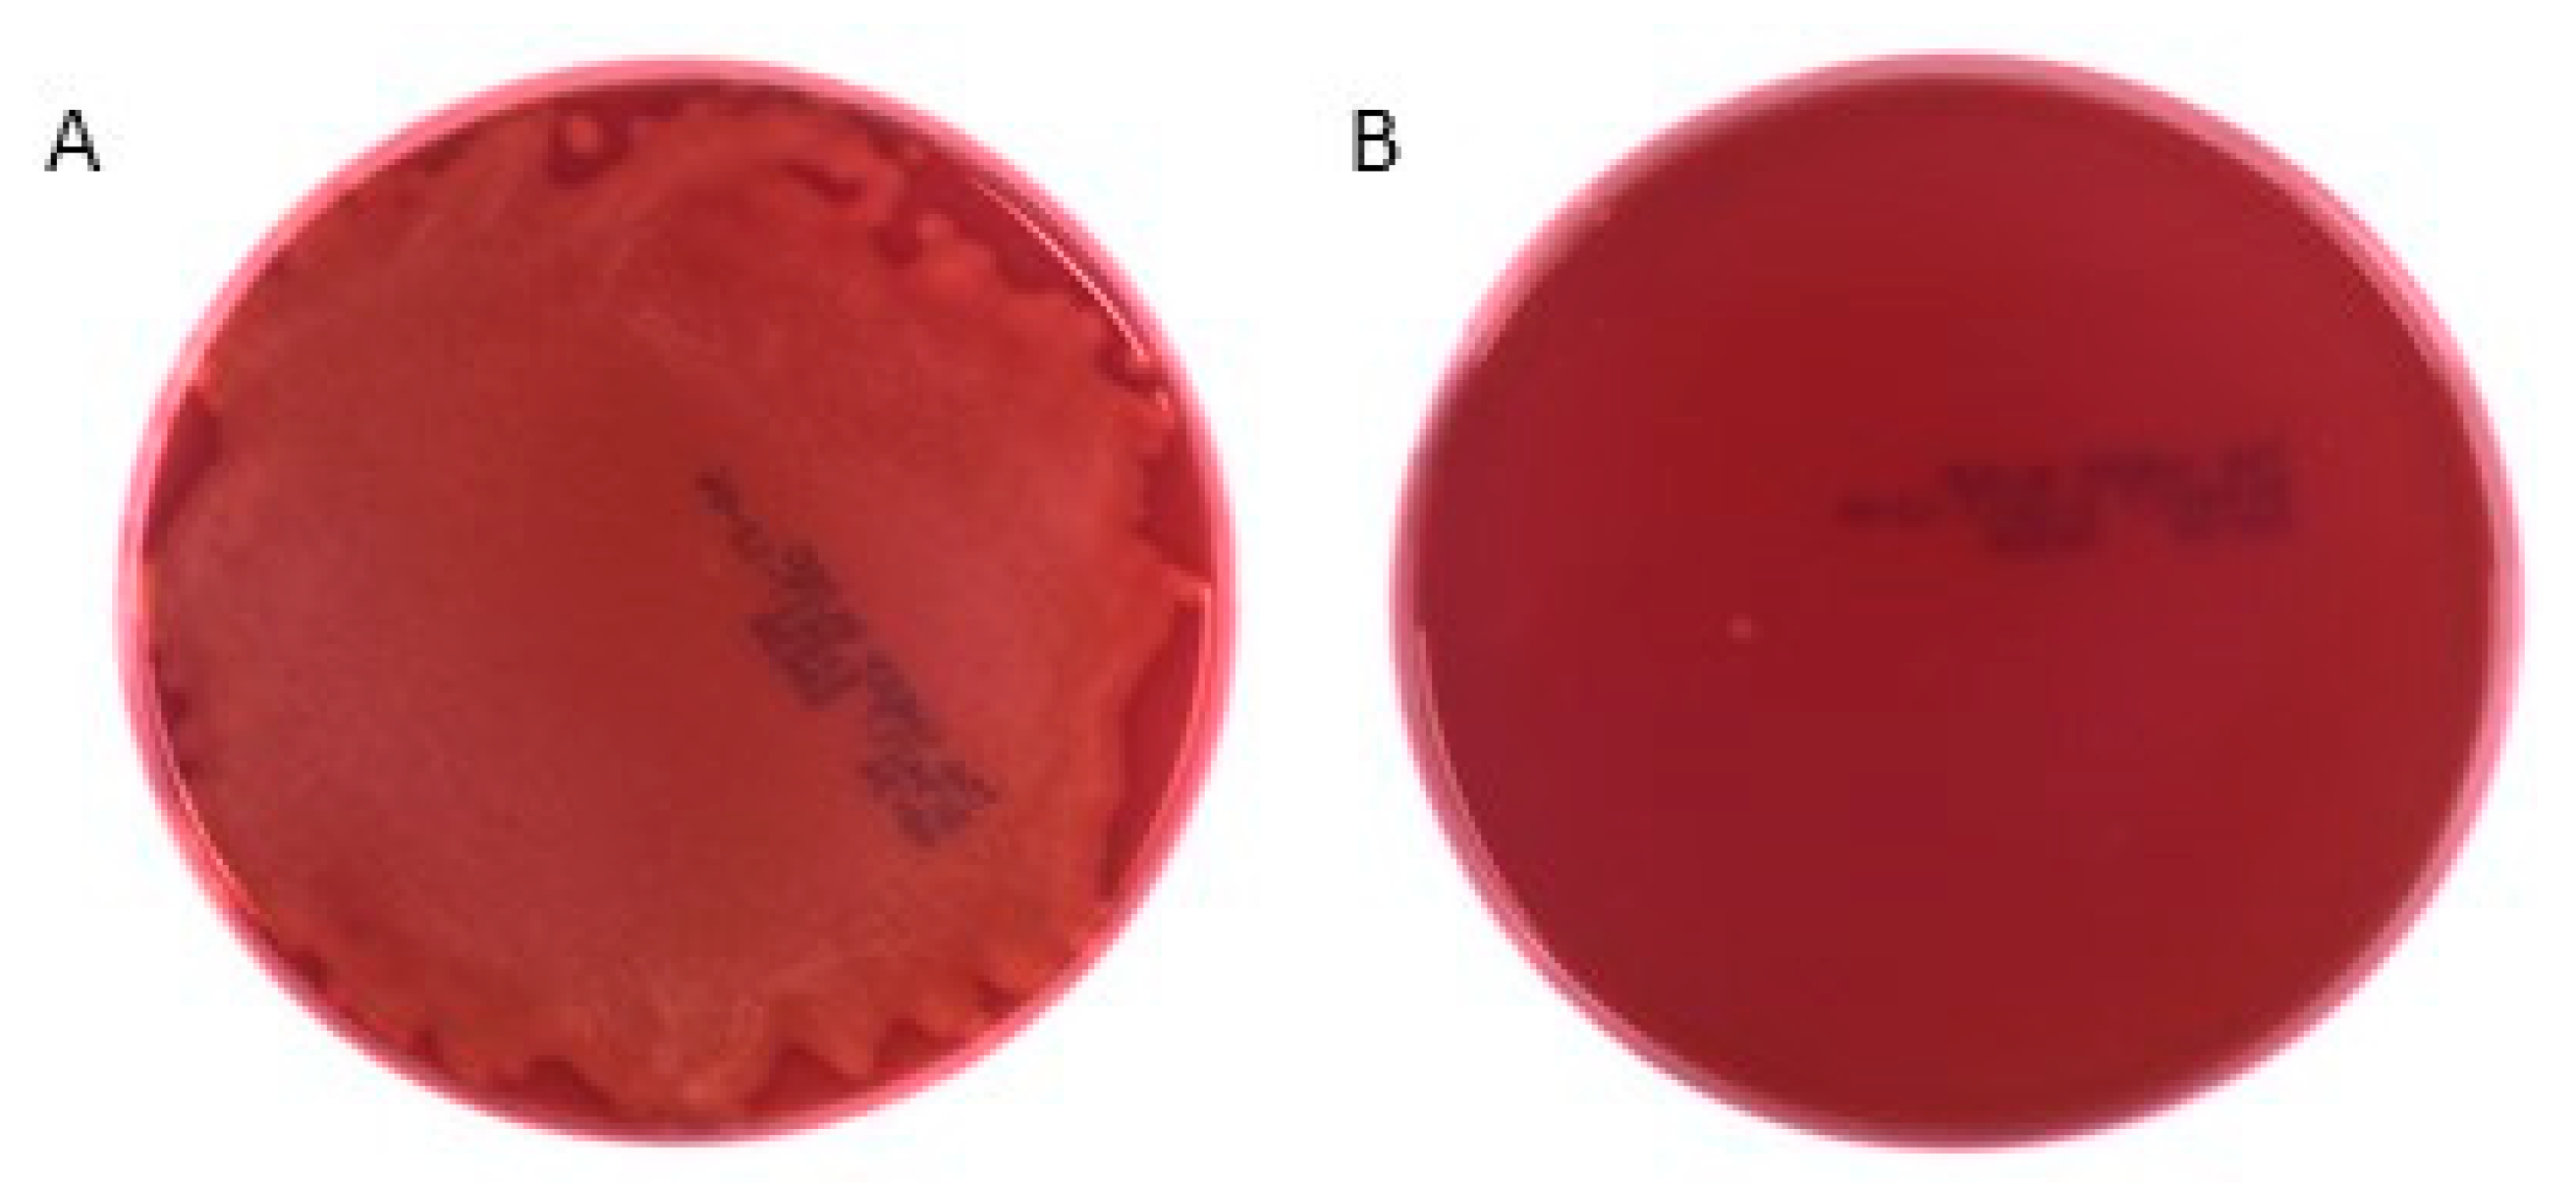
Molecules 25 04558 g006 Molecules 25 04558 g006

1,6-Dehydropinidine Is an Abundant Compound in Picea abies (Pinaceae) Sprouts and 1,6-Dehydropinidine Fraction Shows Antibacterial Activity against Streptococcus equi Subsp. equi
Abstract
1. Introduction
2. Results
2.1. Abundance of 1,6-Dehydropinidine in P. abies
2.2. Antibacterial Activity of 1,6-Dehydropinidine Fraction
3. Discussion
4. Materials and Methods
4.1. Identification of 1,6-Dehydropinidine (2-methyl-6-(2-propenyl)-1,6-piperideine)
4.2. Abundance of 1,6-Dehydropinidine in P. abies
4.3. Isolation of 1,6-Dehydropinidine from P. abies Sprouts
4.4. Antibacterial Activity of 1,6-Dehydropinidine Against Streptococcus Equi Subsp. Equi
5. Conclusions
Supplementary Materials
Author Contributions
Funding
Acknowledgments
Conflicts of Interest
References
- Metsämuuronen, S.; Sirén, H. Bioactive phenolic compounds, metabolism and properties: A review on valuable chemical compounds in Scots pine and Norway spruce. Phytochem. Rev. 2019, 18, 623–664. [Google Scholar] [CrossRef]
- Vainio-Kaila, T.; Zhang, X.; Hänninen, T.; Kyyhkynen, A.; Johansson, L.S.; Willför, S.; Österberg, M.; Siitonen, A.; Rautkari, L. Antibacterial effects of wood structural components and extractives from Pinus sylvestris and Picea abies on methicillin-resistant Staphylococcus aureus and Escherichia coli O157:H7. BioResources 2017, 12, 7601–7614. [Google Scholar] [CrossRef]
- Jokinen, J.J.; Sipponen, A. Refined spruce resin to treat chronic wounds: Rebirth of an old folkloristic therapy. Adv. Wound Care 2016, 5, 198–207. [Google Scholar] [CrossRef] [PubMed]
- Tawara, J.N.; Blokhin, A.; Foderaro, T.A.; Stermitz, F.R.; Hope, H. Toxic piperidine alkaloids from pine (Pinus) and spruce (Picea) trees. New structures and a biosynthetic hypothesis. J. Org. Chem. 1993, 58, 4813–4818. [Google Scholar] [CrossRef]
- Shtykova, L.; Masuda, M.; Eriksson, C.; Sjödin, K.; Marling, E.; Schlyter, F.; Nydén, M. Latex coatings containing antifeedants: Formulation, characterization and application for protection of conifer seedlings against pine weevil feeding. Prog. Org. Coat. 2008, 63, 160–166. [Google Scholar] [CrossRef]
- Cushnie, T.P.T.; Cushnie, B.; Lamb, A.J. Alkaloids: An overview of their antibacterial, antibiotic-enhancing and antivirulence activities. Int. J. Antimicrob. Agents 2014, 44, 377–386. [Google Scholar] [CrossRef]
- Tallent, W.H.; Stromberg, V.L.; Horning, E.C. Pinus alkaloids: The alkaloids of P. sabiniana Dougl. and related species. J. Am. Chem. Soc. 1955, 77, 6361–6364. [Google Scholar] [CrossRef]
- Stermitz, F.R.; Tawara, J.N.; Boeckl, M.; Pomeroy, M.; Foderaro, T.A.; Todd, F.G. Piperidine alkaloid content of Picea (spruce) and Pinus (pine). Phytochemistry 1994, 35, 951–953. [Google Scholar] [CrossRef]
- Schneider, M.J.; Brendze, S.; Montali, J.A. Alkaloids of Picea breweriana. Phytochemistry 1995, 39, 1387–1390. [Google Scholar] [CrossRef]
- Virjamo, V.; Julkunen-Tiitto, R. Pinaceae alkaloids. In Plant Specialized Metabolism: Genomics, Biochemistry and Biological Functions, 1st ed.; Arimura, G., Maffei, M., Eds.; CRC Book: Boca Raton, FL, USA, 2017; pp. 119–130. [Google Scholar]
- Virjamo, V.; Julkunen-Tiitto, R.; Henttonen, H.; Hiltunen, E.; Karjalainen, R.; Korhonen, J.; Huitu, O. Differences in vole preference, secondary chemistry and nutrient levels between naturally regenerated and planted Norway spruce seedlings. J. Chem. Ecol. 2013, 39, 1322–1334. [Google Scholar] [CrossRef]
- Virjamo, V.; Julkunen-Tiitto, R. Shoot development of Norway spruce (Picea abies) involves changes in volatile alkaloids and condensed tannins. Trees 2014, 28, 427–437. [Google Scholar] [CrossRef]
- Veličkovic′, D.; Liao, H.L.; Vilgalys, R.; Chu, R.K.; Anderton, C.R. Spatiotemporal transformation in the alkaloid profile of Pinus roots in response to mycorrhization. J. Nat. Prod. 2019, 82, 1382–1386. [Google Scholar] [CrossRef] [PubMed]
- Tawara, J.N.; Stermitz, F.R.; Blokhin, A.V. Alkaloids of young ponderosa pine seedlings and the late steps in the biosynthesis of pinidine. Phytochemistry 1995, 39, 705–708. [Google Scholar] [CrossRef]
- Tawara, J. Chemical Analyses of Picea and Pinus (Pinaceae) and Biosynthetic Studies on Pinus Ponderosa Alkaloids. Ph.D. Dissertation, Colorado State University, Ft. Collins, CO, USA, 1994. [Google Scholar]
- Gerson, E.A.; Kelsey, R.G. Piperidine alkaloids in North American Pinus taxa: Implications for chemosystematics. Biochem. System. Ecol. 2004, 32, 62–74. [Google Scholar] [CrossRef]
- Gerson, E.A.; Kelsey, R.G. Piperidine alkaloids in nitrogen fertilized Pinus ponderosa. J. Chem. Ecol. 1999, 25, 2027–2039. [Google Scholar] [CrossRef]
- Gerson, E.A.; Kelsey, R.G.; St Clair, J.B. Genetic variation of piperidine alkaloids in Pinus ponderosa: A common garden study. Ann. Bot. 2009, 103, 447–457. [Google Scholar] [CrossRef]
- Virjamo, V.; Sutinen, S.; Julkunen-Tiitto, R. Combined effect of elevated UVB, elevated temperature and fertilization on growth, needle structure and phytochemistry of young Norway spruce (Picea abies) seedlings. Glob. Chang. Biol. 2014, 20, 2252–2260. [Google Scholar] [CrossRef]
- Virjamo, V.; Julkunen-Tiitto, R. Variation in piperidine alkaloid chemistry of Norway spruce (Picea abies) foliage in diverse geographic origins grown at the same area. Can. J. For. Res. 2016, 46, 456–460. [Google Scholar] [CrossRef]
- Arias Gutierrez, M.P. Strangles: The most prevalent infectious respiratory disease in horses worldwide. Ces. Med. Vet. Zootec. 2013, 8, 143–159. [Google Scholar]
- Fonseca, J.D.; Mavrides, D.E.; Morgan, A.L.; Na, J.G.; Graham, P.A.; McHugh, T.D. Antibiotic resistance in bacteria associated with equine respiratory disease in the United Kingdom. Vet. Rec. 2020, 187, 1–6. [Google Scholar] [CrossRef]
- Virjamo, V.; Julkunen-Tiitto, R. Quality and quantity of piperidine alkaloids in needles and bark of Scots pine (Pinus sylvestris) seedlings. Phytochem. Lett. 2018, 26, 106–109. [Google Scholar] [CrossRef]
- Gerson, E.A.; Kelsey, R.G. Foliar storage and extraction methods for quantitative analysis of piperidine alkaloids from Ponderosa pine (Pinus ponderosa). Phytochem. Anal. 1999, 10, 322–327. [Google Scholar] [CrossRef]
- Jörgensen, J.H.; Ferraro, M.J. Antimicrobial susceptibility testing: Special needs for fastidious organisms and difficult-to-detect resistance mechanisms. Clin. Infect. Dis. 2000, 30, 799–808. [Google Scholar] [CrossRef] [PubMed]
- Fyhrquist, P.; Virjamo, V.; Hiltunen, E.; Julkunen-Tiitto; Epidihydropinidine, R. The main piperidine alkaloid compound of Norway spruce (Picea abies) shows antibacterial and anti-Candida activity. Fitoterapia 2019, 134, 503–511. [Google Scholar] [CrossRef]
- Piippo, S. Luonnon lääkeyrtit 2; Kustannusosakeyhtiö Tammi: Hämeenlinna, Finland, 2004; pp. 211–212. (In Finnish) [Google Scholar]
- Ganthaler, A.; Stöggl, W.; Kranner, I.; Mayr, S. Foliar phenolic compounds in Norway spruce with varying susceptibility to Chrysomyxa rhododendri: Analyses of seasonal and infection-induced accumulation patterns. Front. Plant. Sci. 2017, 8, 1173. [Google Scholar] [CrossRef] [PubMed]
- Schönwitz, R.; Lohwasser, K.; Kloos, M.; Ziegler, H. Seasonal variation in the monoterpenes in needles of Picea abies (L.) Karst. Trees 1990, 4, 34–40. [Google Scholar] [CrossRef]
- Stermitz, F.R.; Lorenz, P.; Tawara, J.N.; Zenewicz, L.A.; Lewis, K. Synergy in a medicinal plant: Antimicrobial action of berberine potentiated by 5’-methoxyhydnocarpin, a multidrug pump inhibitor. Proc. Natl. Acad. Sci. USA 2000, 97, 1433–1437. [Google Scholar] [CrossRef]
- Taulavuori, K.; Julkunen-Tiitto, R.; Hyöky, V.; Taulavuori, E. Blue Mood for Superfood. Nat. Prod. Commun. 2013, 8, 791–794. [Google Scholar] [CrossRef]
- Salih, E.; Kanninen, M.; Sipi, M.; Luukkanen, O.; Hiltunen, R.; Vuorela, H.; Julkunen-Tiitto, R.; Fyhrquist, P. Tannins, flavonoids and stilbenes in extracts of African savanna woodland trees Terminalia brownii, Terminalia laxiflora and Anogeissus leiocarpus showing promising antibacterial potential. S. Afr. J. Bot. 2017, 108, 370–386. [Google Scholar] [CrossRef]
Sample Availability: Samples of the compounds are not available from the authors. |

| Factor | p-Value | Effect | Data Reference |
|---|---|---|---|
| Plant part (bark vs. needles) | 0.653 1 | [11] | |
| Needle age (first visible, developing, mature) | 0.0002 | ↑ in early needles | [12] |
| Tree origin (12 origins, see Table 2) | 0.0092 | no clear pattern | [20] |
| UV-radiation (ambient vs. +33% UVB) | 0.093 1 | [19] | |
| Temperature (ambient vs. +2 °C) | 0.937 1 | [19] | |
| Fertilization (ambient vs. fertilized) | 0.310 1 | [19] |
| Origin | mg g−1 (dw) | Tukey′s HSD | |
|---|---|---|---|
| Northern Finland | N68°E24° | 0.16 ± 0.03 | a |
| N67°E23° | 0.25 ± 0.04 | ab | |
| Central Finland | N63°E29° | 0.33 ± 0.04 | ab |
| N64°E28° | 0.34 ± 0.04 | ab | |
| Southern Finland | N61°E23° | 0.26 ± 0.04 | ab |
| N60°E23° | 0.24 ± 0.03 | ab | |
| Russia | N61°E40° | 0.25 ± 0.06 | ab |
| Latvia | N56°E25° | 0.38 ± 0.05 | b |
| Poland | N53°E23° | 0.29 ± 0.04 | ab |
| Slovakia | N48°E20° | 0.20 ± 0.04 | ab |
| France | N48°E6° | 0.29 ± 0.05 | ab |
| Romania | N47°E25° | 0.19 ± 0.03 | ab |
| Piperidine Alkaloid Compounds from P. abies | Correlation Coefficient | |
|---|---|---|
| Early trans-piperidines | 1,6-dehydropinidinone | 0.605 ** |
| epipinidinone | 0.480 ** | |
| 1,6-dehydropinidinol | 0.671 ** | |
| Early cis-piperidines | pinidinone | 0.758 ** |
| 1,2-dehydropinidinone | 0.663 ** | |
| 1,2-dehydropinidinol | 0.082 | |
| Late trans-piperidines | 2-methyl-6-propyl-1,6-piperideine | 0.190 |
| epidihydropinidine | 0.094 | |
| trans-pinidine | 0.054 | |
| trans-pinidinol | 0.072 | |
| Late cis-piperidines | euphococcinine | 0.769 ** |
| cis-pinidinol | −0.10 | |
© 2020 by the authors. Licensee MDPI, Basel, Switzerland. This article is an open access article distributed under the terms and conditions of the Creative Commons Attribution (CC BY) license (http://creativecommons.org/licenses/by/4.0/).
Share and Cite
Virjamo, V.; Fyhrquist, P.; Koskinen, A.; Lavola, A.; Nissinen, K.; Julkunen-Tiitto, R. 1,6-Dehydropinidine Is an Abundant Compound in Picea abies (Pinaceae) Sprouts and 1,6-Dehydropinidine Fraction Shows Antibacterial Activity against Streptococcus equi Subsp. equi. Molecules 2020, 25, 4558. https://doi.org/10.3390/molecules25194558
Virjamo V, Fyhrquist P, Koskinen A, Lavola A, Nissinen K, Julkunen-Tiitto R. 1,6-Dehydropinidine Is an Abundant Compound in Picea abies (Pinaceae) Sprouts and 1,6-Dehydropinidine Fraction Shows Antibacterial Activity against Streptococcus equi Subsp. equi. Molecules. 2020; 25(19):4558. https://doi.org/10.3390/molecules25194558
Chicago/Turabian StyleVirjamo, Virpi, Pia Fyhrquist, Akseli Koskinen, Anu Lavola, Katri Nissinen, and Riitta Julkunen-Tiitto. 2020. "1,6-Dehydropinidine Is an Abundant Compound in Picea abies (Pinaceae) Sprouts and 1,6-Dehydropinidine Fraction Shows Antibacterial Activity against Streptococcus equi Subsp. equi" Molecules 25, no. 19: 4558. https://doi.org/10.3390/molecules25194558
APA StyleVirjamo, V., Fyhrquist, P., Koskinen, A., Lavola, A., Nissinen, K., & Julkunen-Tiitto, R. (2020). 1,6-Dehydropinidine Is an Abundant Compound in Picea abies (Pinaceae) Sprouts and 1,6-Dehydropinidine Fraction Shows Antibacterial Activity against Streptococcus equi Subsp. equi. Molecules, 25(19), 4558. https://doi.org/10.3390/molecules25194558

